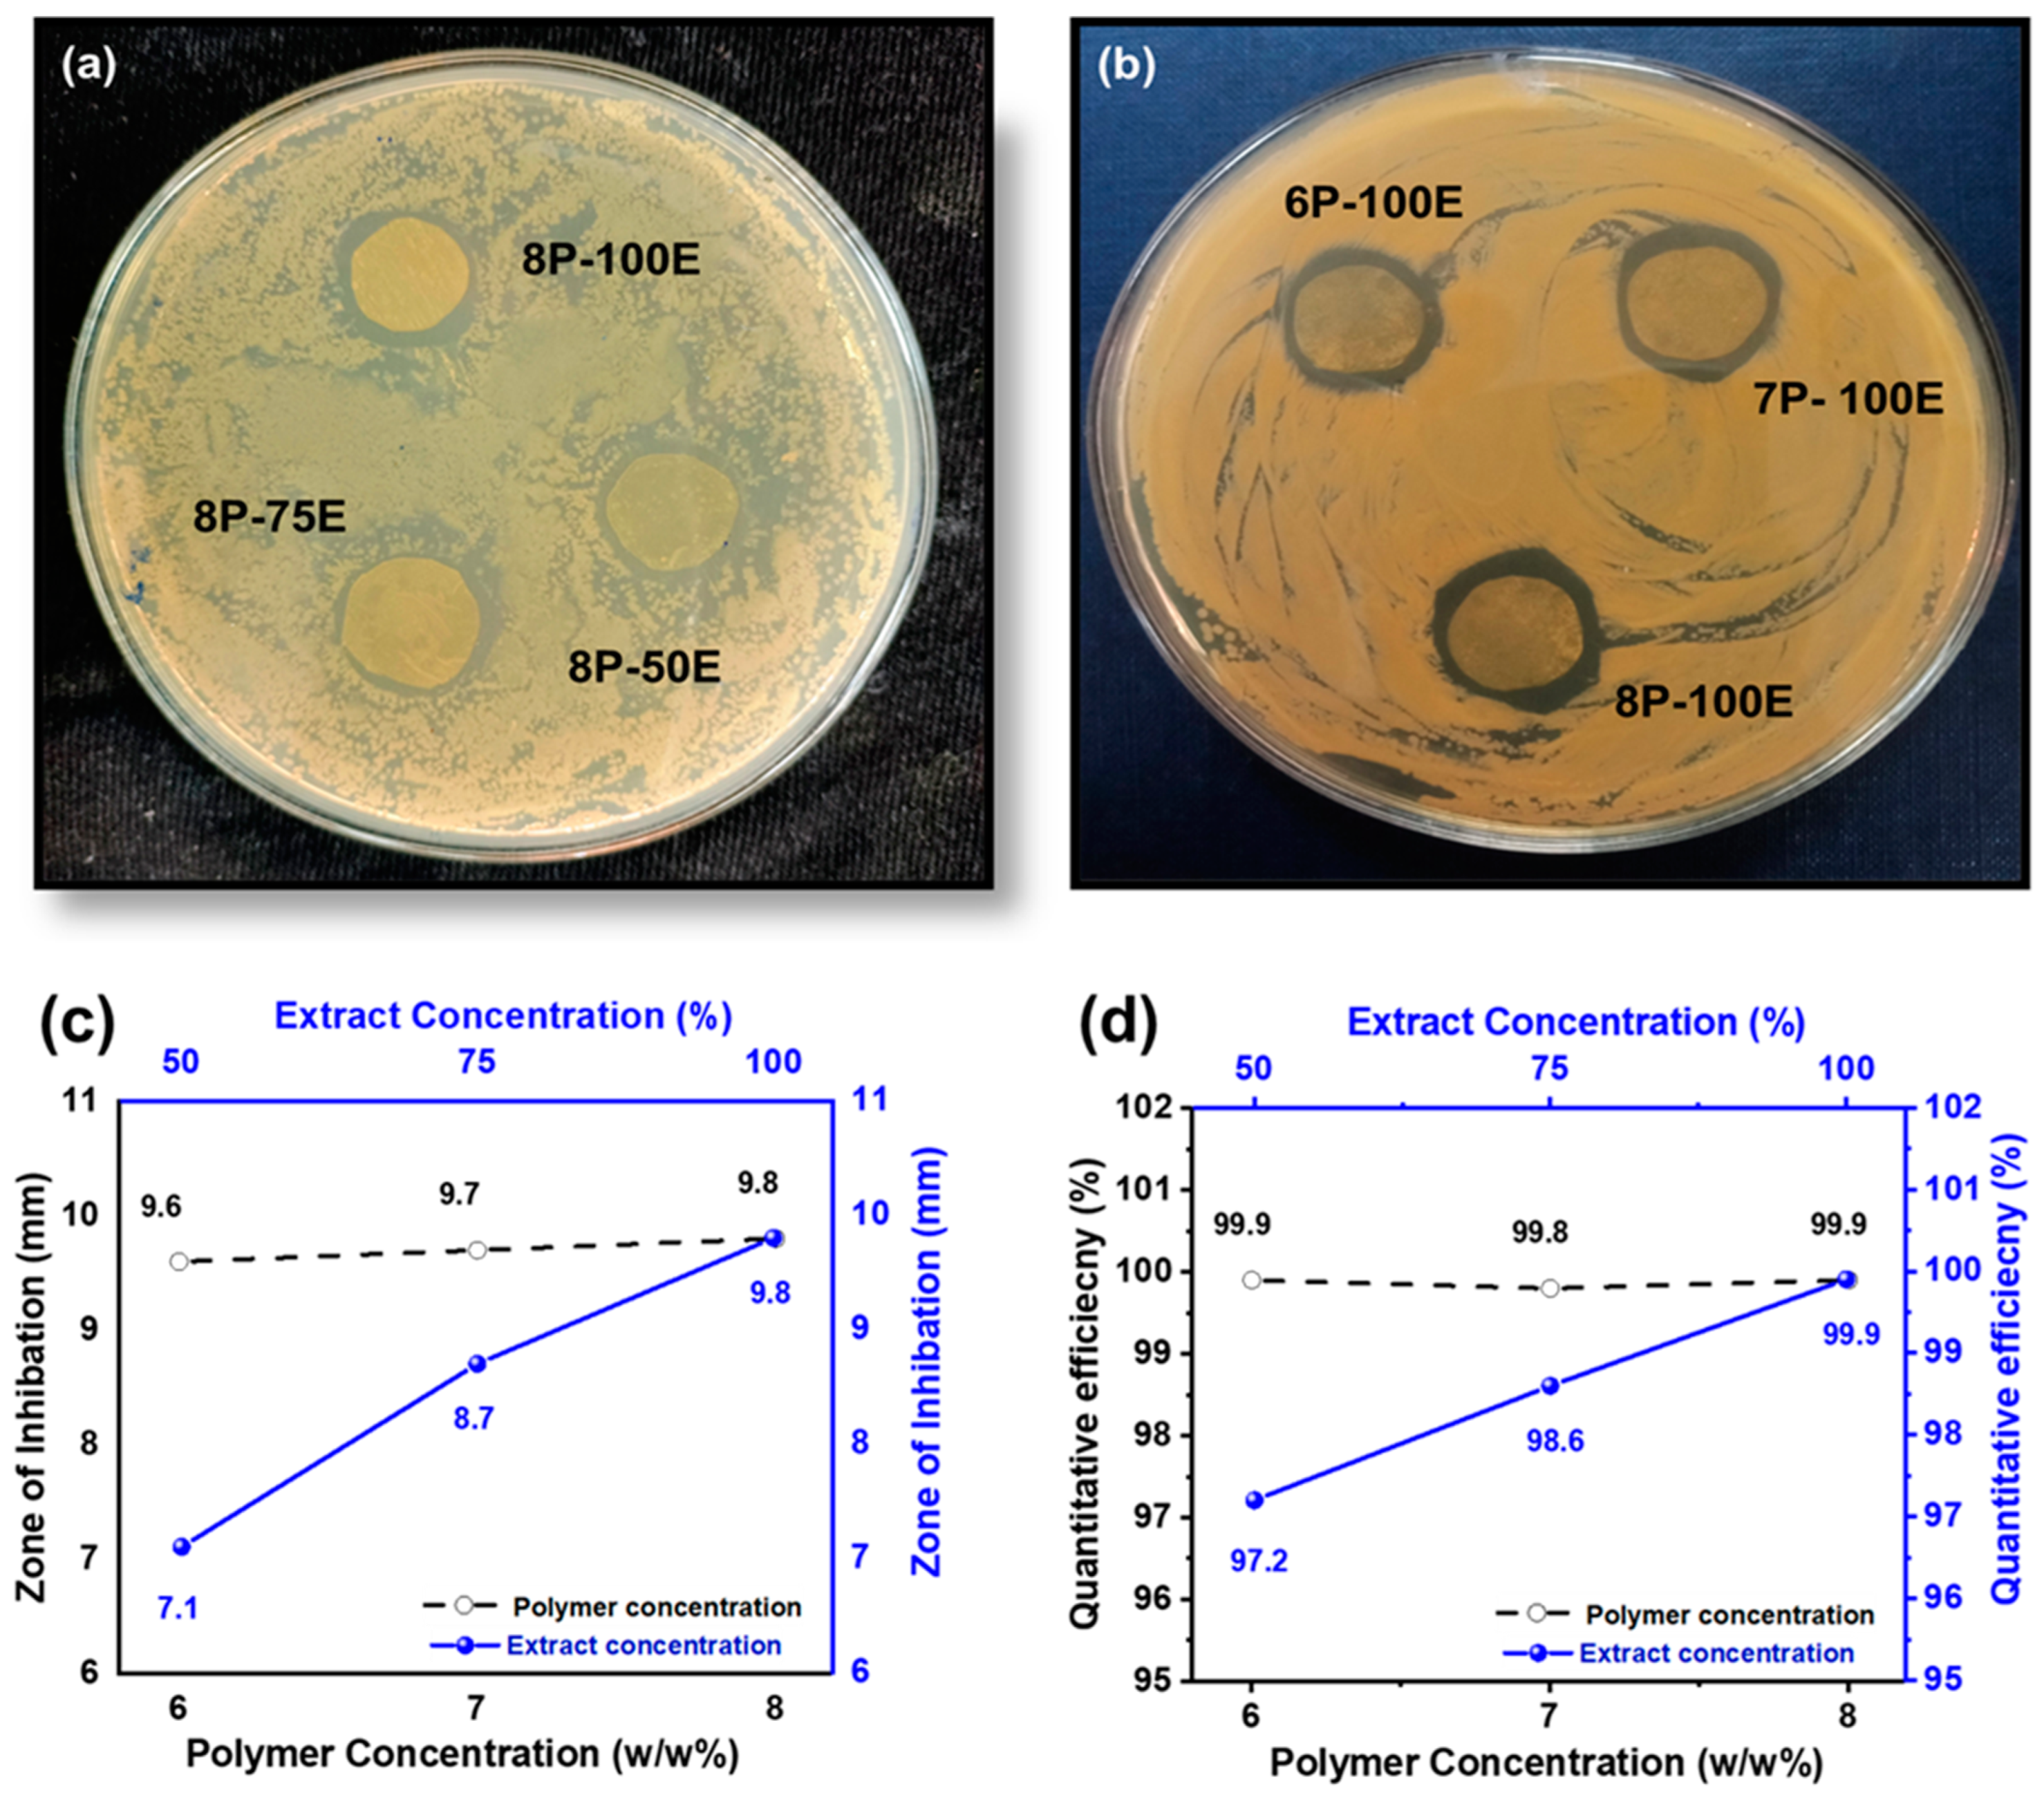
Membranes 13 00156 g008 Membranes 13 00156 g008

Development of Sustainable Hydrophilic Azadirachta indica Loaded PVA Nanomembranes for Cosmetic Facemask Applications
Abstract
1. Introduction
2. Materials and Methods
2.1. Materials
2.2. Extraction of AI Juice
2.3. Preparation of Electrospinning Solution
2.4. Functional Nanofibrous Membrane Fabrication through Electrospinning
2.5. Characterization and Techniques
3. Results and Discussions
3.1. Surface Morphology
3.2. Chemical Composition through FTIR & Particle Size and Distribution
3.3. Mechanical Properties and Air Permeability Testing
3.4. Hydrophobicity Study through Water Contact Angle & Swelling Behavior of the Developed Sheets
3.5. In Vitro Drug Release Study & Radical Scavenging Activity through DPPH
3.6. Skin Patch Testing
3.7. In Vitro Antimicrobial Activities
4. Conclusions
Author Contributions
Funding
Institutional Review Board Statement
Informed Consent Statement
Data Availability Statement
Acknowledgments
Conflicts of Interest
References
- Hendriks, F.M.; Brokken, D.; Oomens, C.W.J.; Bader, D.L.; Baaijens, F.P.T. The relative contributions of different skin layers to the mechanical behavior of human skin in vivo using suction experiments. Med. Eng. Phys. 2006, 28, 259–266. [Google Scholar] [CrossRef]
- Egawa, M.; Oguri, M.; Kuwahara, T.; Takahashi, M. Effect of exposure of human skin to a dry environment. Ski. Res. Technol. 2002, 8, 212–218. [Google Scholar] [CrossRef]
- Najafi, M.; Lemon, S.M.; O’Connor, S.; Knobler, S.L. The Infectious Etiology of Chronic Diseases: Defining the Relationship, Enhancing the Research, and Mitigating the Effects: Workshop Summary; National Academies Press: Washington, DC, USA, 2004. [Google Scholar]
- Kakehashi, S.; Stanley, H.R.; Fitzgerald, R.J. The effects of surgical exposures of dental pulps in germ-free and conventional laboratory rats. Oral Surg. Oral Med. Oral Pathol. 1965, 20, 340–349. [Google Scholar] [CrossRef]
- Parish, L.C.; Crissey, J.T. Cosmetics: A historical review. Clin. Dermatol. 1988, 6, 1–4. [Google Scholar] [CrossRef]
- Morganti, P.; Yudin, V.E.; Morganti, G.; Coltelli, M.-B. Trends in Surgical and Beauty Masks for a Cleaner Environment. Cosmetics 2020, 7, 68. [Google Scholar] [CrossRef]
- Afonso, C.R.; Hirano, R.S.; Gaspar, A.L.; Chagas, E.G.L.; Carvalho, R.A.; Silva, F.V.; Leonardi, G.R.; Lopes, P.S.; Silva, C.F.; Yoshida, C.M.P. Biodegradable antioxidant chitosan films useful as an anti-aging skin mask. Int. J. Biol. Macromol. 2019, 132, 1262–1273. [Google Scholar] [CrossRef]
- Katz, L.M.; Valenzuela, C.; Sadrieh, N.K. Reporting cosmetic adverse events to the US Food and Drug Administration. Dermatitis 2016, 27, 236–237. [Google Scholar] [CrossRef]
- Pradeep, H.K.; Patel, D.H.; Onkarappa, H.S.; Pratiksha, C.C.; Prasanna, G.D. Role of nanocellulose in industrial and pharmaceutical sectors—A review. Int. J. Biol. Macromol. 2022, 207, 1038–1047. [Google Scholar] [CrossRef]
- Perugini, P.; Bleve, M.; Redondi, R.; Cortinovis, F.; Colpani, A. In vivo evaluation of the effectiveness of biocellulose facial masks as active delivery systems to skin. J. Cosmet. Dermatol. 2020, 19, 725–735. [Google Scholar] [CrossRef]
- Ajalloueian, F.; Asgari, S.; Guerra, P.R.; Chamorro, C.I.; Ilchenco, O.; Piqueras, S.; Fossum, M.; Boisen, A. Amoxicillin-loaded multilayer pullulan-based nanofibers maintain long-term antibacterial properties with tunable release profile for topical skin delivery applications. Int. J. Biol. Macromol. 2022, 215, 413–423. [Google Scholar] [CrossRef] [PubMed]
- Lu, J.; Chen, Y.; Ding, M.; Fan, X.; Hu, J.; Chen, Y.; Li, J.; Li, Z.; Liu, W. A 4arm-PEG macromolecule crosslinked chitosan hydrogels as antibacterial wound dressing. Carbohydr. Polym. 2022, 277, 118871. [Google Scholar] [CrossRef]
- Zhang, K.-Q.; Deng, Q.-F.; Luo, J.; Gong, C.-L.; Chen, Z.-G.; Zhong, W.; Hu, S.-Q.; Wang, H.-F. Multifunctional Ag(I)/CAAA-Amidphos Complex-Catalyzed Asymmetric [3 + 2] Cycloaddition of α-Substituted Acrylamides. ACS Catal. 2021, 11, 5100–5107. [Google Scholar] [CrossRef]
- Ajazzuddin, M.; Jeswani, G.; Kumar Jha, A. Nanocosmetics: Past, present and future trends. Recent Pat. Nanomed. 2015, 5, 3–11. [Google Scholar] [CrossRef]
- Pal, N.; Agarwal, M.; Gupta, R. Green synthesis of guar gum/Ag nanoparticles and their role in peel-off gel for enhanced antibacterial efficiency and optimization using RSM. Int. J. Biol. Macromol. 2022, 221, 665–678. [Google Scholar] [CrossRef]
- Ahmad, A.; Khan, M.A.; Nazir, A.; Arshad, S.N.; Qadir, M.B.; Khaliq, Z.; Khan, Z.S.; Satti, A.N.; Mushtaq, B.; Shahzad, A. Triaxial electrospun mixed-phased TiO2 nanofiber-in-nanotube structure with enhanced photocatalytic activity. Microporous Mesoporous Mater. 2021, 320, 111104. [Google Scholar] [CrossRef]
- Khan, M.A.; Ahmad, A.; Arshad, S.N.; Nazir, A.; Ahmad, S.; Khan, M.Q.; Shahzad, A.; Satti, A.N.; Qadir, M.B.; Khaliq, Z. Development of optimized triaxially electrospun titania nanofiber-in-nanotube core-shell structure. J. Appl. Polym. Sci. 2021, 138, 50562. [Google Scholar] [CrossRef]
- Qadir, M.B.; Jalalah, M.; Shoukat, M.U.; Ahmad, A.; Khaliq, Z.; Nazir, A.; Anjum, M.N.; Rahman, A.; Khan, M.Q.; Tahir, R.; et al. Nonwoven/Nanomembrane Composite Functional Sweat Pads. Membranes 2022, 12, 1230. [Google Scholar] [CrossRef]
- Wu, R.; Tan, Y.; Meng, F.; Zhang, Y.; Huang, Y.-X. PVDF/MAF-4 composite membrane for high flux and scaling-resistant membrane distillation. Desalination 2022, 540, 116013. [Google Scholar] [CrossRef]
- Fathi-Azarbayjani, A.; Qun, L.; Chan, Y.W.; Chan, S.Y. Novel vitamin and gold-loaded nanofiber facial mask for topical delivery. AAPS PharmSciTech 2010, 11, 1164–1170. [Google Scholar] [CrossRef]
- Javaid, A.; Jalalah, M.; Safdar, R.; Khaliq, Z.; Qadir, M.B.; Zulfiqar, S.; Ahmad, A.; Satti, A.N.; Ali, A.; Faisal, M.; et al. Ginger Loaded Polyethylene Oxide Electrospun Nanomembrane: Rheological and Antimicrobial Attributes. Membranes 2022, 12, 1148. [Google Scholar] [CrossRef]
- Meng, Y. A Sustainable Approach to Fabricating Ag Nanoparticles/PVA Hybrid Nanofiber and Its Catalytic Activity. Nanomaterials 2015, 5, 1124–1135. [Google Scholar] [CrossRef]
- Lin, S.; Wang, R.Z.; Yi, Y.; Wang, Z.; Hao, L.M.; Wu, J.H.; Hu, G.H.; He, H. Facile and green fabrication of electrospun poly(vinyl alcohol) nanofibrous mats doped with narrowly dispersed silver nanoparticles. Int. J. Nanomed. 2014, 9, 3937–3947. [Google Scholar] [CrossRef]
- Huang, Z.-M.; Zhang, Y.Z.; Kotaki, M.; Ramakrishna, S. A review on polymer nanofibers by electrospinning and their applications in nanocomposites. Compos. Sci. Technol. 2003, 63, 2223–2253. [Google Scholar] [CrossRef]
- Hulupi, M.; Haryadi, H. Synthesis and characterization of electrospinning PVA nanofiber-crosslinked by glutaraldehyde. Mater. Today Proc. 2019, 13, 199–204. [Google Scholar] [CrossRef]
- Adeli, H.; Khorasani, M.T.; Parvazinia, M. Wound dressing based on electrospun PVA/chitosan/starch nanofibrous mats: Fabrication, antibacterial and cytocompatibility evaluation and in vitro healing assay. Int. J. Biol. Macromol. 2019, 122, 238–254. [Google Scholar] [CrossRef] [PubMed]
- Zhang, W.; Guan, X.; Qiu, X.; Gao, T.; Yu, W.; Zhang, M.; Song, L.; Liu, D.; Dong, J.; Jiang, Z.; et al. Bioactive composite Janus nanofibrous membranes loading Ciprofloxacin and Astaxanthin for enhanced healing of full-thickness skin defect wounds. Appl. Surf. Sci. 2023, 610, 155290. [Google Scholar] [CrossRef]
- Yang, R.; Hou, E.; Cheng, W.; Yan, X.; Zhang, T.; Li, S.; Yao, H.; Liu, J.; Guo, Y. Membrane-Targeting Neolignan-Antimicrobial Peptide Mimic Conjugates to Combat Methicillin-Resistant Staphylococcus aureus (MRSA) Infections. J. Med. Chem. 2022, 65, 16879–16892. [Google Scholar] [CrossRef] [PubMed]
- Chen, Y.; Li, J.; Lu, J.; Ding, M.; Chen, Y. Synthesis and properties of Poly(vinyl alcohol) hydrogels with high strength and toughness. Polym. Test. 2022, 108, 107516. [Google Scholar] [CrossRef]
- Askari, P.; Zahedi, P.; Rezaeian, I. Three-layered electrospun PVA/PCL/PVA nanofibrous mats containing tetracycline hydrochloride and phenytoin sodium: A case study on sustained control release, antibacterial, and cell culture properties. J. Appl. Polym. Sci. 2016, 133, 43309. [Google Scholar] [CrossRef]
- Mehta, P.; Picken, H.; White, C.; Howarth, K.; Langridge, K.; Nazari, K.; Taylor, P.; Qutachi, O.; Chang, M.w.; Ahmad, Z. Engineering optimisation of commercial facemask formulations capable of improving skin moisturisation. Int. J. Cosmet. Sci. 2019, 41, 462–471. [Google Scholar] [CrossRef]
- Xu, H.; Wu, Z.; Zhao, D.; Liang, H.; Yuan, H.; Wang, C. Preparation and characterization of electrospun nanofibers-based facial mask containing hyaluronic acid as a moisturizing component and huangshui polysaccharide as an antioxidant component. Int. J. Biol. Macromol. 2022, 214, 212–219. [Google Scholar] [CrossRef]
- Hindi, N.K.K.; Al-Hasnawy, H.H.; Kadhum, S.A. Antibacterial activity of some plant essential oils against pathogenic bacteria with the efficacy of zinc oxide ointment against some skin infection. Biochem. Cell Arch. 2018, 18, 189–195. [Google Scholar]
- Sharma, C.; Bhardwaj, N.K. Fabrication of natural-origin antibacterial nanocellulose films using bio-extracts for potential use in biomedical industry. Int. J. Biol. Macromol. 2020, 145, 914–925. [Google Scholar] [CrossRef] [PubMed]
- Jones, F.A. Herbs–useful plants. Their role in history and today. Eur. J. Gastroenterol. Hepatol. 1996, 8, 1227–1231. [Google Scholar] [CrossRef]
- Al Akeel, R.; Mateen, A.; Janardhan, K.; Gupta, V.C. Analysis of anti-bacterial and anti oxidative activity of Azadirachta indica bark using various solvents extracts. Saudi J. Biol. Sci. 2017, 24, 11–14. [Google Scholar] [CrossRef]
- Mistry, K.S.; Sanghvi, Z.; Parmar, G.; Shah, S. The antimicrobial activity of Azadirachta indica, Mimusops elengi, Tinospora cardifolia, Ocimum sanctum and 2% chlorhexidine gluconate on common endodontic pathogens: An in vitro study. Eur. J. Dent. 2014, 08, 172–177. [Google Scholar] [CrossRef]
- Ali, A.; Shahid, M.A.; Hossain, M.D.; Islam, M.N. Antibacterial bi-layered polyvinyl alcohol (PVA)-chitosan blend nanofibrous mat loaded with Azadirachta indica (neem) extract. Int. J. Biol. Macromol. 2019, 138, 13–20. [Google Scholar] [CrossRef] [PubMed]
- Ali, A.; Shahid, M. Polyvinyl alcohol (PVA)–Azadirachta indica (Neem) nanofibrous mat for biomedical application: Formation and characterization. J. Polym. Environ. 2019, 27, 2933–2942. [Google Scholar] [CrossRef]
- Lin, J.-H.; Shiu, B.-C.; Hsu, P.-W.; Lou, C.-W.; Lin, J.-H. PVP/CS/Phyllanthus emblica Nanofiber Membranes for Dry Facial Masks: Manufacturing Process and Evaluations. Polymers 2022, 14, 4470. [Google Scholar] [CrossRef]
- Lee, K.; Lee, S. Electrospun Nanofibrous Membranes with Essential Oils for Wound Dressing Applications. Fibers Polym. 2020, 21, 999–1012. [Google Scholar] [CrossRef]
- Gulseren Sakarya, B.; Erdi, B. Obtaining a New Generation Skin Mask for Cosmetic Applications. J. Mater. Electron. Devices 2021, 7, 25–33. [Google Scholar]
- Xu, Y.; Xie, L.; Hou, T.; Wang, D.; Zhang, T.; Li, C. Preparation and Properties of Asymmetric Polyvinyl Pyrroli-Done/Polycaprolactone Composite Nanofiber Loaded with Tea Tree Extract. Polymers 2022, 14, 3714. [Google Scholar] [CrossRef]
- Food and Drug Administration. Cosmetic Product Formulation and Frequency of Use Data; FDA Database: White Oak, MI, USA, 1984.
- Jatoi, A.W.; Ogasawara, H.; Kim, I.S.; Ni, Q.-Q. Polyvinyl alcohol nanofiber based three phase wound dressings for sustained wound healing applications. Mater. Lett. 2019, 241, 168–171. [Google Scholar] [CrossRef]
- Alani, J.I.; Davis, M.D.P.; Yiannias, J.A. Allergy to cosmetics: A literature review. Dermatitis 2013, 24, 283–290. [Google Scholar] [CrossRef] [PubMed]
- Basketter, D.A.; Whittle, E.; Griffiths, H.A.; York, M. The identification and classification of skin irritation hazard by a human patch test. Food Chem. Toxicol. 1994, 32, 769–775. [Google Scholar] [CrossRef] [PubMed]
- Basketter, D.; Gilpin, G.; Kuhn, M.; Lawrence, D.; Reynolds, F.; Whittle, E. Patch tests versus use tests in skin irritation risk assessment. Contact Dermat. 1998, 39, 252–256. [Google Scholar] [CrossRef] [PubMed]
- Elkasaby, M.; Hegab, H.A.; Mohany, A.; Rizvi, G.M. Modeling and optimization of electrospinning of polyvinyl alcohol (PVA). Adv. Polym. Technol. 2018, 37, 2114–2122. [Google Scholar] [CrossRef]
- Kharazmi, A.; Faraji, N.; Hussin, R.M.; Saion, E.; Yunus, W.M.M.; Behzad, K. Structural, optical, opto-thermal and thermal properties of ZnS–PVA nanofluids synthesized through a radiolytic approach. Beilstein J. Nanotechnol. 2015, 6, 529–536. [Google Scholar] [CrossRef] [PubMed]
- Gutha, Y.; Pathak, J.L.; Zhang, W.; Zhang, Y.; Jiao, X. Antibacterial and wound healing properties of chitosan/poly (vinyl alcohol)/zinc oxide beads (CS/PVA/ZnO). Int. J. Biol. Macromol. 2017, 103, 234–241. [Google Scholar] [CrossRef] [PubMed]
- Fan, J.-P.; Luo, J.-J.; Zhang, X.-H.; Zhen, B.; Dong, C.-Y.; Li, Y.-C.; Shen, J.; Cheng, Y.-T.; Chen, H.-P. A novel electrospun β-CD/CS/PVA nanofiber membrane for simultaneous and rapid removal of organic micropollutants and heavy metal ions from water. Chem. Eng. J. 2019, 378, 122232. [Google Scholar] [CrossRef]
- Abdel-Hady, E.E.; Mohamed, H.F.M.; Abdel-Hamed, M.O.; Gomaa, M.M. Physical and electrochemical properties of PVA/TiO2 nanocomposite membrane. Adv. Polym. Technol. 2018, 37, 3842–3853. [Google Scholar] [CrossRef]
- Taha, A.; Ben Aissa, M.; Da’na, E. Green synthesis of an activated carbon-supported Ag and ZnO nanocomposite for photocatalytic degradation and its antibacterial activities. Molecules 2020, 25, 1586. [Google Scholar] [CrossRef]
- Elzey, B.; Pollard, D.; Fakayode, S.O. Determination of adulterated neem and flaxseed oil compositions by FTIR spectroscopy and multivariate regression analysis. Food Control 2016, 68, 303–309. [Google Scholar] [CrossRef]
- Riyajan, S.-A.; Chantawee, K. Cassava starch composite based films for encapsulated neem: Effect of carboxylated styrene-butadiene rubber coating. Food Packag. Shelf Life 2020, 23, 100438. [Google Scholar] [CrossRef]
- Ulaeto, S.B.; Mathew, G.M.; Pancrecious, J.K.; Nair, J.B.; Rajan, T.P.D.; Maiti, K.K.; Pai, B.C. Biogenic Ag nanoparticles from neem extract: Their structural evaluation and antimicrobial effects against Pseudomonas nitroreducens and Aspergillus unguis (NII 08123). ACS Biomater. Sci. Eng. 2019, 6, 235–245. [Google Scholar] [CrossRef] [PubMed]
- Ngadiman, N.H.A.; Noordin, M.Y.; Idris, A.; Shakir, A.S.A.; Kurniawan, D. Influence of polyvinyl alcohol molecular weight on the electrospun nanofiber mechanical properties. Procedia Manuf. 2015, 2, 568–572. [Google Scholar] [CrossRef]
- Eichhorn, S.J.; Sampson, W.W. Statistical geometry of pores and statistics of porous nanofibrous assemblies. J. R. Soc. Interface 2005, 2, 309–318. [Google Scholar] [CrossRef] [PubMed]
- Ahmad, A.; Ali, U.; Nazir, A.; Shahzad, A.; Khaliq, Z.; Qadir, M.B.; Khan, M.A.; Ali, S.; Hassan, M.A.; Abid, S. Toothed wheel needleless electrospinning: A versatile way to fabricate uniform and finer nanomembrane. J. Mater. Sci. 2019, 54, 13834–13847. [Google Scholar] [CrossRef]
- Jalalah, M.; Ahmad, A.; Saleem, A.; Qadir, M.B.; Khaliq, Z.; Khan, M.Q.; Nazir, A.; Faisal, M.; Alsaiari, M.; Irfan, M. Electrospun Nanofiber/Textile Supported Composite Membranes with Improved Mechanical Performance for Biomedical Applications. Membranes 2022, 12, 1158. [Google Scholar] [CrossRef] [PubMed]
- Sun, K.C.; Arbab, A.A.; Sahito, I.A.; Qadir, M.B.; Choi, B.J.; Kwon, S.C.; Yeo, S.Y.; Yi, S.C.; Jeong, S.H. A PVdF-based electrolyte membrane for a carbon counter electrode in dye-sensitized solar cells. RSC Adv. 2017, 7, 20908–20918. [Google Scholar] [CrossRef]
- Zahedi, P.; Rezaeian, I.; Jafari, S.H.; Karami, Z. Preparation and release properties of electrospun poly (vinyl alcohol)/poly (ɛ-caprolactone) hybrid nanofibers: Optimization of process parameters via D-optimal design method. Macromol. Res. 2013, 21, 649–659. [Google Scholar] [CrossRef]
- Sa’adon, S.; Abd Razak, S.I.; Fakhruddin, K. Drug-loaded poly-vinyl alcohol electrospun nanofibers for transdermal drug delivery: Review on factors affecting the drug release. Procedia Comput. Sci. 2019, 158, 436–442. [Google Scholar] [CrossRef]
- Taepaiboon, P.; Rungsardthong, U.; Supaphol, P. Drug-loaded electrospun mats of poly (vinyl alcohol) fibres and their release characteristics of four model drugs. Nanotechnology 2006, 17, 2317. [Google Scholar] [CrossRef]
- Kim, K.-O.; Akada, Y.; Kai, W.; Kim, B.-S.; Kim, I.-S. Cells attachment property of PVA hydrogel nanofibers incorporating hyaluronic acid for tissue engineering. J. Biomater. Nanobiotechnol. 2011, 2, 353. [Google Scholar] [CrossRef]
- El-Hefian, E.A.; Nasef, M.M.; Yahaya, A.H. The preparation and characterization of chitosan/poly (vinyl alcohol) blended films. E-J. Chem. 2010, 7, 1212–1219. [Google Scholar] [CrossRef]
- Abid, S.; Hussain, T.; Raza, Z.A.; Nazir, A. Current applications of electrospun polymeric nanofibers in cancer therapy. Mater. Sci. Eng. C 2019, 97, 966–977. [Google Scholar] [CrossRef] [PubMed]
- Li, T.-T.; Yan, M.; Zhong, Y.; Ren, H.-T.; Lou, C.-W.; Huang, S.-Y.; Lin, J.-H. Processing and characterizations of rotary linear needleless electrospun polyvinyl alcohol (PVA)/Chitosan (CS)/Graphene (Gr) nanofibrous membranes. J. Mater. Res. Technol. 2019, 8, 5124–5132. [Google Scholar] [CrossRef]
- Salam, A.; Khan, M.Q.; Hassan, T.; Hassan, N.; Nazir, A.; Hussain, T.; Azeem, M.; Kim, I.S. In-vitro assessment of appropriate hydrophilic scaffolds by co-electrospinning of poly (1, 4 cyclohexane isosorbide terephthalate)/polyvinyl alcohol. Sci. Rep. 2020, 10, 19751. [Google Scholar] [CrossRef]
- Khoshnevisan, K.; Maleki, H.; Samadian, H.; Doostan, M.; Khorramizadeh, M.R. Antibacterial and antioxidant assessment of cellulose acetate/polycaprolactone nanofibrous mats impregnated with propolis. Int. J. Biol. Macromol. 2019, 140, 1260–1268. [Google Scholar] [CrossRef]
- Lobo, R.; Pimpliskar, M.R.; Jadhav, R.N. Essential Oils of Azadirachta Indica and Vitex Negundo Leaves Evaluation for Phytochemical Analysis, Antioxidant Activity and Antimicrobial Activity. Int. J. Recent Sci. Res. 2018, 9, 28284–28289. [Google Scholar]
- Ali, S.M.; Yosipovitch, G. Skin pH: From basic science to basic skin care. Acta Derm.-Venereol. 2013, 93, 261–269. [Google Scholar] [CrossRef]
- Khampieng, T.; Wnek, G.E.; Supaphol, P. Electrospun DOXY-h loaded-poly (acrylic acid) nanofiber mats: In vitro drug release and antibacterial properties investigation. J. Biomater. Sci. Polym. Ed. 2014, 25, 1292–1305. [Google Scholar] [CrossRef]
- Uhljar, L.É.; Kan, S.Y.; Radacsi, N.; Koutsos, V.; Szabó-Révész, P.; Ambrus, R. In vitro drug release, permeability, and structural test of ciprofloxacin-loaded nanofibers. Pharmaceutics 2021, 13, 556. [Google Scholar] [CrossRef] [PubMed]
- Zamani, M.; Morshed, M.; Varshosaz, J.; Jannesari, M. Controlled release of metronidazole benzoate from poly ε-caprolactone electrospun nanofibers for periodontal diseases. Eur. J. Pharm. Biopharm. 2010, 75, 179–185. [Google Scholar] [CrossRef]
- Basketter, D.; Chamberlain, M.; Griffiths, H.; Rowson, M.; Whittle, E.; York, M. The classification of skin irritants by human patch test. Food Chem. Toxicol. 1997, 35, 845–852. [Google Scholar] [CrossRef] [PubMed]
- Nigam, P.K. Adverse reactions to cosmetics and methods of testing. Indian J. Dermatol. Venereol. Leprol. 2009, 75, 8–10. [Google Scholar] [CrossRef]
- Alavarse, A.C.; de Oliveira Silva, F.W.; Colque, J.T.; da Silva, V.M.; Prieto, T.; Venancio, E.C.; Bonvent, J.-J. Tetracycline hydrochloride-loaded electrospun nanofibers mats based on PVA and chitosan for wound dressing. Mater. Sci. Eng. C 2017, 77, 271–281. [Google Scholar] [CrossRef]
- Francine, U.; Jeannette, U.; Pierre, R.J. Assessment of antibacterial activity of neem plant (Azadirachta indica) on Staphylococcus aureus and Escherichia coli. J. Med. Plants Stud. 2015, 3, 85–91. [Google Scholar]
- Swaroop, K.; Francis, S.; Somashekarappa, H.M. Gamma irradiation synthesis of Ag/PVA hydrogels and its antibacterial activity. Mater. Today Proc. 2016, 3, 1792–1798. [Google Scholar] [CrossRef]

| Sr | Sample Code | PVA Concentration (wt%) | AI Extract Concentration (%) |
|---|---|---|---|
| 1 | 6P-100E | 6 | 100 |
| 2 | 7P-100E | 7 | 100 |
| 3 | 8P-100E | 8 | 100 |
| 4 | 8P-75E | 8 | 75 |
| 5 | 8P-50E | 8 | 50 |
| Sample | Type of Allergy | Response |
|---|---|---|
| 8P-100E (PVA 8% + AI 100%) | Redness | 0 |
| Irritation | 0 | |
| Sensitivity | 0 |
Disclaimer/Publisher’s Note: The statements, opinions and data contained in all publications are solely those of the individual author(s) and contributor(s) and not of MDPI and/or the editor(s). MDPI and/or the editor(s) disclaim responsibility for any injury to people or property resulting from any ideas, methods, instructions or products referred to in the content. |
© 2023 by the authors. Licensee MDPI, Basel, Switzerland. This article is an open access article distributed under the terms and conditions of the Creative Commons Attribution (CC BY) license (https://creativecommons.org/licenses/by/4.0/).
Share and Cite
Tahir, R.; Albargi, H.B.; Ahmad, A.; Qadir, M.B.; Khaliq, Z.; Nazir, A.; Khalid, T.; Batool, M.; Arshad, S.N.; Jalalah, M.; et al. Development of Sustainable Hydrophilic Azadirachta indica Loaded PVA Nanomembranes for Cosmetic Facemask Applications. Membranes 2023, 13, 156. https://doi.org/10.3390/membranes13020156
Tahir R, Albargi HB, Ahmad A, Qadir MB, Khaliq Z, Nazir A, Khalid T, Batool M, Arshad SN, Jalalah M, et al. Development of Sustainable Hydrophilic Azadirachta indica Loaded PVA Nanomembranes for Cosmetic Facemask Applications. Membranes. 2023; 13(2):156. https://doi.org/10.3390/membranes13020156
Chicago/Turabian StyleTahir, Rizwan, Hasan B. Albargi, Adnan Ahmad, Muhammad Bilal Qadir, Zubair Khaliq, Ahsan Nazir, Tanzeela Khalid, Misbah Batool, Salman Noshear Arshad, Mohammed Jalalah, and et al. 2023. "Development of Sustainable Hydrophilic Azadirachta indica Loaded PVA Nanomembranes for Cosmetic Facemask Applications" Membranes 13, no. 2: 156. https://doi.org/10.3390/membranes13020156
APA StyleTahir, R., Albargi, H. B., Ahmad, A., Qadir, M. B., Khaliq, Z., Nazir, A., Khalid, T., Batool, M., Arshad, S. N., Jalalah, M., Alsareii, S. A., & Harraz, F. A. (2023). Development of Sustainable Hydrophilic Azadirachta indica Loaded PVA Nanomembranes for Cosmetic Facemask Applications. Membranes, 13(2), 156. https://doi.org/10.3390/membranes13020156

